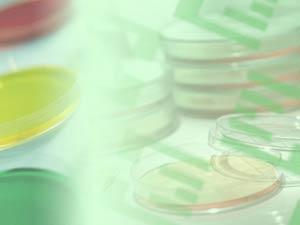
Petri Dish Title Content PowerPoint Template Petri Dish Title Content PowerPoint Template

Download this template, plus more (25 in all)
A Petri dish is a shallow glass or plastic cylindrical dish that biologists use to culture cells. Glass Petri dishes can be re-used by sterilization (for example, dry heating in a hot air oven at 160 °C for one hour); plastic Petri dishes must be disposed of after use. This Petri Dish PowerPoint Theme or template is to a large degree colored multicolored. The download includes a Title slide that's coordinated with other slide layouts.
To use this Petri Dish 02 Theme or template for PowerPoint, you need to be running:
Microsoft and the Office logo are trademarks or registered trademarks of Microsoft Corporation in the United States and/or other countries.